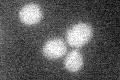
YKR105C
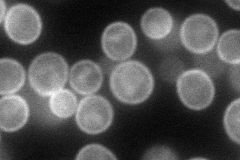
YKR105C
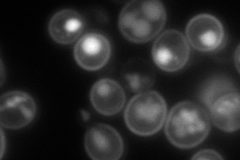
YKR105C
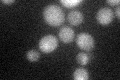
YKR105C

View description
Putative transporter of the Major Facilitator Superfamily (MFS); proposed role as a basic amino acid permease based on phylogeny
Localization:
Intensity:
Fold change:
Significance:
-
C’ GFP library in SD
below threshold14.74 -
N' NOP1pr-GFP in SD
cell periphery88.9368 -
N' TEF2pr-mCherry in SD
cell periphery,vacuole177.796 -
N' NATIVEpr-GFP in SD

below threshold18.8794 -
N' TEF2pr-VC and Cyto-VN in SD

cell periphery,punctate34.3298 -
C’ GFP library in SD+DTT
cytosol13.780.93No -
C’ GFP library in SD+H2O2

cytosol151.01No -
C’ GFP library in Starvation Media

cytosol15.581.05No -
C’ GFP library on the background of Pup2-DaMP

below threshold -
C’ GFP library on the background of CCT mutant

below threshold15.0291.0191No
